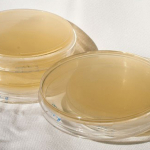

Applications
Application Notes
Checking the content uniformity of tablets is a crucial step in quality control of these dosage forms—but it is slow and tedious. With IR laser imaging a comprehensive content uniformity is finally possible in less than 10 min.
Bruker Optics GmbH & Co. KGA multiparameter determination within one minute using NIR spectroscopy.
Metrohm AGIR spectroscopy of aqueous samples can be challenging due to the strong absorbance of water, however, horizontal multibounce ATR gives sufficient sensitivity.
Specac LtdThe in situ characterisation of protein unfolding, including intermediate conformations is the holy grail for a host of biological questions.
Specac LtdThe Pearl™ FT-IR transmission accessory is used to analyse milk to meet quality control standards.
Specac LtdLearn how the High Temperature Golden Gate™ ATR has been used with a fast time‑resolved IR laser spectrometer to yield important insights into reaction kinetics.
Specac LtdThis application note describes the quantification of Simeticone according to European Pharmacopoeia Standard 10.0 (01/2017:1470) using the Specac Pearl™.
Specac LtdThis application note presents how and if NIR spectroscopy can be used to identify optimal and sub-optimal lots of powdered gelatine agar.
ABB Measurement & AnalyticsThe thermal reaction of IPA on CeO2 catalysts has been investigated over a range of temperatures using the Selector™ Environmental Chamber accessory.
Specac LtdDetailed analysis of the temperature-induced changes in the spectra can be used to obtain insights into the phase behaviour of mixtures such as the soaps described in this application.
Specac LtdThis application note demonstrates the use of IR laser imaging for tissue analysis and the tremendous speed advantages associated with it.
Bruker Optics GmbH & Co. KGOperando infrared spectroscopy was used to unravel CO2 activation of supported Ni catalysts in Specac’s HTHP cell.
Specac LtdThe Quest ATR with heated puck is used for the analysis of butter and its transition from solid to liquid phase.
Specac LtdATR-FTIR spectroscopy is very useful to characterise the chemistry of dental bonding systems.
Specac LtdThis note demonstrates the use of the Arrow silicon ATR system for batch, long-duration experiments on paint samples following the principles of ASTM STP1119.
Specac LtdThis application note provides an introduction to the principles of laser locking in general and to the more practical aspects of phase and frequency locking of diode lasers.
TOPTICA Photonics AGThis note discusses the benefits of the various standard and patented grating design technologies, and the general grating parameters that can be controlled.
Wasatch PhotonicsFor rapid qualitative analysis of liquid samples, a liquid film can be formed by simply squeezing the sample between two windows without the need for a spacer.
Specac LtdDisposable ATR slides have particular benefits when analysing packaging adhesives.
Specac LtdDiamond ATR provides a simple and effective alternative to KBr pellets for the infrared analysis of powders.
Specac Ltd